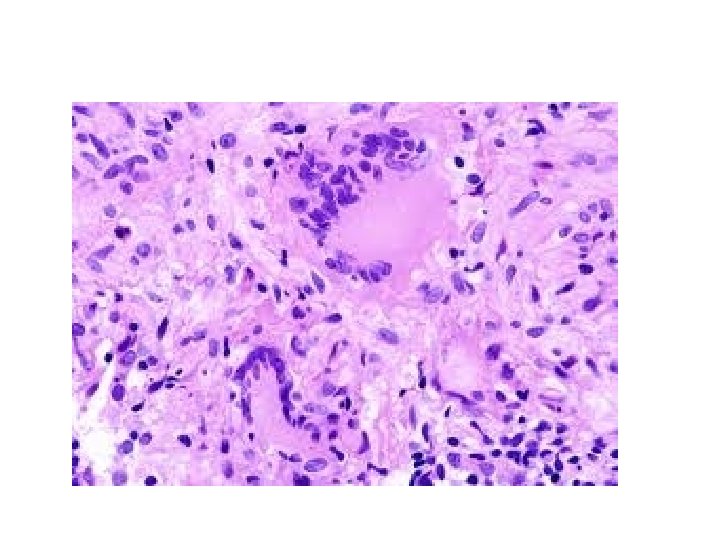

MYCOBACTERIA Professor Shagufta Hussain Mycobacterium rodshaped aerobic bacteria

MYCOBACTERIA Professor Shagufta Hussain

Mycobacterium • • rod-shaped aerobic bacteria Non sporing. Slow growing Fastidious growth requirements Gram positive(do not stain readily) acid-fast" bacilli. Intra cellular pathogens (macrophages)

Species of mycobacterium • Mycobacterium tuberculosis --tuberculosis • Mycobacterium bovis----- tuberculosis • Mycobacterium africanum----- tuberculosis TB complex • Atypical mycobacteria(MOTT) (opportunistic) • more than 50 Mycobacterium species, including many that are saprophytes • Mycobacterium leprae -----leprosy.

Pathogenicity of Mycobacteria • Humans and guinea pigs are highly susceptible to M tuberculosis infection, fowl and cattle are resistant • M tuberculosis and Mycobacterium bovis are equally pathogenic for humans. route of infection (respiratory versus intestinal) • "Atypical" mycobacteria MOTT(eg, Mycobacterium kansasii) produce human disease indistinguishable from tuberculosis; • others (eg, Mycobacterium fortuitum) cause only surface lesions or act as opportunists


CLINICAL FINDINGS • Fatigue, weakness, weight loss, and fever may be signs of tuberculous disease. • Pulmonary involvement giving rise to chronic cough and spitting of blood • Meningitis or urinary tract involvement can occur in the absence of other signs of tuberculosis. • Bloodstream dissemination leads to miliary tuberculosis with lesions in many organs and a high mortality rate.

INTRODUCTION TO TUBERCULOSIS • Someone infected with tuberculosis every second. • One third of the world's population infected with Tuberculosis Complex bacteria. • Left untreated, one person will infect 10 -15 people per year.

Great concern WHO reports • death with "multi-drug resistant TB" M. D. R. T. U. S. 70 percent. • Diagnosis to death: four to sixteen weeks. • 90 million new tuberculosis cases • 30 million deaths worldwide. • Strikes all races, ages, and income levels. • Higher risk. HIV infection, Close contacts of infectious TB Poor; Homeless , Prisoners, Alcoholics, Elderly & Health care workers.

TB &PAKISTAN • Estimated TB deaths in 2009 were 1. 3 million • Pakistan ranks sixth among countries with a high TB burden. • Prevalence of TB in Pakistan is 420, 000 and incidence is 231 per 100, 000 population/ year

TB &PAKISTAN • Harbors 63% of the TB burden in the Eastern Mediterranean Region of WHO. • 420, 000 new TB cases emerge every year and among those Half are sputum smear positive.

WHO declared TB a global emergency in 1993 Government of Pakistan endorsed in 1995 Directly Observed Treatment Strategy (DOTS)

Morphology & Identification • Thin straight rods (beaded) 0. 4 x 3 um • Coccoid and filamentous variable morphology in species. • Gram-positive or Gram-negative ? ?

Ziehl-Neelsen stain ---"acidfastness • 95% ethyl alcohol containing 3% hydrochloric acid (acid-alcohol) quickly decolorizes all bacteria except the mycobacteria. • Depends on the integrity of the waxy envelope.

http: //www. ihcworld. com/royellis/gallery/zn. htm

Fluorochrome stains Auramine, Rhodamine Mycobacteria can be demonstrated by yellow-orange fluorescence

Culture • primary culture of mycobacterium should include • nonselective medium • selective medium. ( Selective media contain antibiotics to prevent the overgrowth of contaminating bacteria and fungi. )

Inspissated Egg Media Löwenstein-Jensen • contain defined salts, glycerol, and complex organic substances (eg, fresh eggs or egg yolks, potato flour, etc. ). • Malachite green ----to inhibit other bacteria. • antibiotics are used in selective media • Small inoccula in specimens from patients will grow on these media in 3– 6 weeks.


Semi synthetic Agar Media • Middlebrook 7 H 10 and 7 H 11 contain defined salts, vitamins, cofactors, oleic acid, albumin, catalase, and glycerol • 7 H 11 medium contains casein hydrolysate • Albumin neutralizes the toxic and inhibitory effects of fatty acids in the specimen or medium.

Uses of semi synthetic agar • large inocula necessary less sensitive than other media for primary isolation of mycobacteria. • used for observing colony morphology • susceptibility testing • with added antibiotics and malachite green, as selective media.

Broth Media • Middlebrook 7 H 9 and 7 H 12 • support the proliferation of small inocula. mycobacteria grow in clumps or masses because of the hydrophobic . • If Tweens (water-soluble esters of fatty acids) wet the surface permit dispersed growth in liquid media. • Growth is more rapid than on complex media. character of the cell surface

Growth Characteristics • obligate aerobes • derive energy from the oxidation of many simple carbon compounds. • growth rate slow doubling time 18 hours. • Saprophytic forms grow more rapidly, at 22 – 33 °C, produce more pigment, and less acidfast than pathogenic forms.

Reaction to Physical and Chemical Agents : • More resistant to Chemical agents than other bacteria due to Hydrophobic nature of the cell surface and their clumped growth.

Resistant to: • Dyes (eg, malachite green) • antibacterial agents (eg, penicillin) put into L-J media. • Acids and alkalies • used to eliminate contaminating organisms "concentration" of clinical specimens. • resistant to drying and survive for long periods in dried sputum

Constituents of Tubercle Bacilli • Lipids 60% • Proteins • Polysaccharides

Lipids • Mycolic acids (long-chain fatty acids C 78– C 90) Acid fastness • Waxes wax D Adjuvant • Phosphatides. Caseous necrosis • Phthiocerol dimycocerosate lung lesions

Lipids • largely bound to proteins and polysaccharides. • Muramyl dipeptide (from peptidoglycan) complexed with mycolic acids can cause granuloma formation • phospholipids induce caseous necrosis.

Lipids responsible for acid-fastness • removal with hot acid destroys acid-fastness • Acid-fastness lost after sonication of mycobacterial cells (cell wall Broken). • Analysis of lipids by gas chromatography reveals patterns that aid in classification of different species.

"cord factor" • Virulent strains of tubercle bacilli form microscopic "serpentine cords" arranged in parallel chains. • correlated with virulence. • "cord factor" (trehalose-6, 6'-dimycolate) extracted from virulent bacilli with petroleum ether. • inhibits migration of leukocytes, causes chronic granulomas, and can serve as an immunologic "adjuvant. "

Proteins • several proteins • PPD elicit the tuberculin reaction. • Proteins bound to a wax fraction can, upon injection, induce tuberculin sensitivity. • formation of a variety of antibodies against them.

Polysaccharides • variety of polysaccharides • role in disease pathogenesis uncertain. • can induce the immediate type of hypersensitivity • can serve as antigens in reactions with sera of infected persons

Pathogenesis Mycobacteria in droplets 1– 5 µm diameter are inhaled and reach alveoli. .

Droplet nuclei. • contains no more than 3 bacilli. • remain air-borne for extended periods of time. • Generated during talking coughing and sneezing. • • Coughing generates about 3000 droplet nuclei. • Talking for 5 minutes generates 3000 droplet nuclei • singing generates 3000 droplet nuclei in one minute • Sneezing generates the most droplet nuclei which can spread to individuals up to 10 feet away.

PATHOGENESIS

production and healing or progression of lesions determined by: • no of mycobacteria in the inoculum • subsequent multiplication • Resistance and hypersensitivity of the host.

Two Principal Lesions 1. Exudative 2. Granulomatous

Exudative Type • acute inflammatory reaction, with edema fluid, polymorphs leukocytes, and, later, monocytes around the tubercle bacilli. • lung tissue, resembles bacterial pneumonia. • May lead to : 1. resolution, exudate becomes absorbed 2. massive necrosis of tissue 3. secondary (productive) type of lesion. • in this phase, the tuberculin test becomes positive.

Granulomatous Lesion • • chronic granuloma, consists of three zones: (1) central area of large, multinucleated giant cells containing tubercle bacilli (2) mid zone of pale epithelioid cells, often arranged radially (3) peripheral zone of fibroblasts, lymphocytes, and monocytes. Later, peripheral fibrous tissue develops, and the central area undergoes caseation necrosis. Such a lesion is called a tubercle.

Fate of Granuloma • A caseous tubercle may break into a bronchus, empty its contents there, and form a cavity. • may subsequently heal by fibrosis or calcification.

Spread of Organisms in the Host • • • Direct extension Lymphatic channels Bloodstream Via the bronchi Gastrointestinal tract.

Intracellular Site of Growth • Monocytes • Reticuloendothelial cells • Giant cells. intracellular location makes chemotherapy difficult and favors microbial persistence

Types of Tuberculosis Primary Infection or TB After first contact with tubercle bacill: • An acute exudative lesion develops &rapidly spreads to the lymphatics and regional lymph nodes. Lesion often heals rapidly. This lesion is called Ghons complex • The lymph node undergoes massive caseation, which usually calcifies. The tuberculin test becomes positive.

Primary infection what could be the other outcomes? • bacilli may spread to bloodstream, (miliary TB). • Bloodstream can be invaded by erosion of vein by caseating tubercle / lymph node. • caseating lesion discharges into a bronchus, aspirated and distributed to other parts of the lungs • or swallowed and passed into the stomach and intestines

Primary TB • usually in childhood • in adults who have remained free from infection and therefore tuberculin-negative in early life. • may be in any part of the lung but is most often at the base.

Reactivation or secondary TB type usually caused by tubercle bacilli survival in the primary lesion. • characterized by: • chronic tissue lesions, the formation of tubercles, caseation, and fibrosis. • Regional lymph nodes only slightly involved, do not caseate. • almost always begins at the apex of the lung, where the oxygen tension (PO 2) is highest.

Differences between primary infection and reinfection or reactivation are attributed to • (1) resistance and • (2) hypersensitivity induced by the first infection. not clear to what extent each of these components participates in the modified response in reactivation tuberculosis.

Immunity & Hypersensitivity • Cell mediated immunity, mononuclear phagocytes limit the multiplication of ingested organisms and even destroy them • This localizes tubercle bacilli, , limit their spread, and reduce lymphatic dissemination. • hypersensitivity to the tubercle bacilli gives Positive Tuberculin reaction (TYPE IV )

Tuberculin sensitivity • can be induced by whole tubercle bacilli • or by tuberculoprotein in combination with the chloroform-soluble wax D of the tubercle bacillus, • not by tuberculoprotein alone. .

Tuberculin Test • Old tuberculin is a concentrated filtrate of broth in which tubercle bacilli have grown for 6 weeks. • A purified protein derivative (PPD) is obtained by chemical fractionation of old tuberculin. • PPD is standardized in terms of its biologic reactivity as "tuberculin units" (TU).

PPD-S standard for tuberculin • TU is defined as the activity contained in a specified weight of Seibert's PPD Lot No. 49608 in a specified buffer. against which the potency of all products must be established by biologic assay—ie, by reaction size in humans. • 1 TU; • 5 TU; • 250 TU. • Bioequivalency of PPD products based on on comparative activity.

Dose of Tuberculin Local reactions tuberculin tests in surveys employ 5 TU; skin testing is begun with 1 TU More concentrated material (250 TU) administered only if the reaction to 5 TU is negative. • 0. 1 m. L injected intracutaneously. • •

Reactions to Tuberculin • No contact with mycobacteria, no reaction to PPD-S. • primary infection - induration, edema, erythema in 24– 48 hours, very intense reactions, even central necrosis. • read in 48 or 72 hours. • Positive 5 TU ---induration 10 mm or more in diameter. • Positive tests tend to persist for several days. Weak reactions may disappear more rapidly.


Interpretation: Positive Test means a person has been exposed, Negative means Anergy, non exposure defective Cell Mediated Immunity or Miliary Tuberculosis.


tuberculin test • positive within 4– 6 weeks after infection(or BCG). • negative in the presence of tuberculous infection when "anergy“ due to overwhelming tuberculosis, measles, Hodgkin's disease, sarcoidosis, AIDS, or immunosuppression. • A positive tuberculin test may revert to negative upon isoniazid treatment of a recent converter.

Negative Tuberculin test IN BCG • BCG vaccination, convert to a positive test, but this may last for only 3– 7 years • When such persons are retested 2 weeks later, their PPD skin test—"boosted" by the recent antigen injection—will give a positive size of induration again.

TB-Positive CXR Positive PPD + = active TB

Negative CXR Positive PPD + =Latent TB Infection

Miliary (disseminated) TB in an infant Congenital TB may present like this http: //www. hawaii. edu/medicine/pediatrics/pemxray/v 4 c 06 b. jpg

Definitions of positive PPD (Red Book 2009 , p 681) Categories Measurement cut-off 1. Child in close contact with known or suspected contagious TB case 2. Child suspected to have active TB -CXR findings consistent with active or previous untreated, non-healed TB -Clinical evidence of active TB 3. Child immunosuppressed eg HIV or meds ≥ 5 mm 1. Child at increased risk of disseminated TB -<4 yrs old, -other medical conditions eg cancer, diabetes, malnutrition 2. Child with increased exposure to active TB -born in TB-endemic areas -lives with people born in TB-endemic areas -Native American children -frequently exposed to HIV infected adults, homeless, drug users, incarcerated, migrant workers -travel to TB endemic regions ≥ 10 mm 1. Children ≥ 4 yrs with no identifiable risk factors ≥ 15 mm

important Only the elimination of viable tubercle bacilli results in reversion of the tuberculin test to negative

Interpretation of positive Tuberculin Test • Individual infected in past • does not imply that active disease or immunity to disease is present. • persons are at risk of developing disease from reactivation of the primary infection • tuberculin-negative persons who have never been infected are not subject to that risk, though they may become infected from an external source.

Diagnostic Laboratory Tests • • • Specimens fresh sputum gastric washings urine pleural fluid cerebrospinal fluid joint fluid , biopsy material blood, or other suspected material.

Decontamination and Concentration of Specimens • Specimens from sputum and other nonsterile sites liquefied • with N-acetyl-L-cysteine, • decontaminated with Na. OH (kills many other bacteria and fungi), • neutralized with buffer, • and concentrated by centrifugation. .

Deposit Examined -- smears and cultured. • Ziehl-Neelsen staining. • Fluorescence microscopy - auraminerhodamine stain more sensitive than acid-fast stain • presumptive evidence of mycobacterial infection.

• Löwenstein-Jensen • Incubation is at 35– 37 °C in 5– 10% CO 2 for up to 8 weeks.


• If cultures are negative and a positive acidfast stain or slowly growing atypical mycobacteria are suspected • then a set of inoculated media should be incubated at a lower temperature (eg, 24– 33 °C) and both sets incubated for 12 weeks.

Conventional methods for identification of mycobacteria • • • observation of rate of growth colony morphology pigmentation Biochemical Profiles. require 6– 8 weeks for identification.

Biochemical characteristics Positive for • niacin test as with M tuberculosis • Nitrate • Urease • catalase • arylsulfatase test • Molecular probe methods • DNA Detection polymerase chain reaction

Another TB screening test: the IGRA • Interferon gamma release assay – Quantiferon---- TB Gold • Uses specific M TB antigens to stimulate primed T cells • They release inflammatory protein: interferon gamma • IGRA antigens are more specific to M TB, not shared with NTM or BCG vaccine • • • – Not enough data for use in children <4 yrs old – Have replaced PPDs in some institutions/clinics Requires blood sample, processing of live immune cells Need <24 hr delivery to reference lab Call before drawing blood sample to make sure it will get there on time

Runyon Classification of Mycobacteria • GROUP 1 • TB complex • M tuberculosis M africanum M bovis

• 2. Photochromogens produce pigment in light but not in darkness • 3. scotochromogens develop pigment when growing in the dark; • 4. nonchromogens (nonphotochromogens) are nonpigmented or have light tan or buffcolored colonies. • 5. RAPID GROWERS

Runyon Classification • Photochromogens M asiaticum M kansasii M marinum M simiae • Scotochromogens M flavescens M gordonae M scrofulaceum M szulgai • Nonchromogens M avium complex M celatum M haemophilum M gastri M genavense M malmoense M nonchromogenicum M shimoidei M terrae M trivale M ulcerans M xenopi

Growth rate • rapid growers (growth in 7 days) • slow growers

Rapid growers • • • M abscessus M fortuitum group M chelonae group M phlei smegmatis M vaccae

Rapid growers grow in 7 days • • • M fortuitum and M chelonae Cutaneous lesions subcutaneous abscesses disseminated infections M fortuitum is more susceptible to antibiotics

SPECIES ALWAYS CONSIDERED PATHOGENS • M tuberculosis Humans Pulmonary and disseminated tuberculosis; • M bovis Humans, cattle Tuberculosis-like disease • M leprae Humans Leprosy

Treatment of TB • • first-line drugs Isoniazid rifampin. pyrazinamide, ethambutol, streptomycin.

Second-line drugs • • kanamycin, capreomycin, ethionamide, cycloserine, ofloxacin, and ciprofloxacin. toxic or less effective (or both) treatment failure multiple drug resistance

Standard 9 -month regimens • isoniazid and rifampin given daily; pyrazinamide, ethambutol, or streptomycin is given concomitantly until susceptibility test results are known. • In noncompliant patients, directly observed therapy (DOT) is important as well.

Multidrug-resistant tuberculosis (MDR TB) resistant to at least two of the first line anti-TB drugs, isoniazid and rifampicin. Extensively drug resistant TB (XDR TB) is a relatively rare type of MDR TB. XDR TB is defined as TB which is resistant to isoniazid and rifampin, plus resistant to any fluoroquinolone and at least one of three injectable second-line drugs (i. e. , amikacin, kanamycin, or capreomycin). XDR TB is resistant to first-line and second-line drugs, patients are left with less effective treatment options, and cases often have worse treatment outcomes.

Development of MDRT • 1960 s, 1 -2% of isolates were resistant to 2+ drugs. • 1970 s, 3 -5% of isolates were resistant to 2+ drugs. • 1986, no more national drug-resistance surveys. • 1991, 33% of isolates resistant to 1+ drugs, 13% resistant to the 4 front-line drugs. • When resistance to two or more of the first line drugs is detected, additional drugs (ethionamide, streptomycin, ciprofloxacin) may be added to the regimen.

Prevention & Control • (1) treatment of patients • follow-up of contacts with tuberculin tests, xrays, and appropriate treatment are the mainstays of public health tuberculosis control.

Drug treatment of asymptomatic tuberculin-positive • Children contacts of open cases • receive immunosuppressive • starvation, gastrectomy, and suppression of cellular immunity by drugs (eg, corticosteroids) or infection. • HIV infection is a major risk factor for tuberculosis.

Immunization • living avirulent tubercle bacilli, BCG (bacillus Calmette-Guérin, an attenuated bovine organism), • Vaccination substitute for primary infection with virulent tubercle bacilli • BCG is given to children in many countries • The eradication of tuberculosis in cattle and the pasteurization of milk have greatly reduced M bovis infections.

TB: adults vs children • Compared to adults, children: – Tend to develop primary active TB more often after initial infection (0 -4 yrs) – Are more likely to have extrapulmonary disease, especially TB meningitis (0 -4 yrs) – Are more likely to have disseminated TB infection – Are less contagious • Paucibacillary disease (fewer organisms) • Cannot cough/spread infection as well – Are more difficult to diagnose • May not show typical symptoms • May have TB disease in unexpected places – Have less FDA-approved treatment meds and formulation options

TB: adults vs children • A child with active TB is an indicator of an unidentified contagious adult/adolescent with TB – Contact investigation: Public Health staff – Many other children may be diagnosed this way (2680%, vs 3 -25% by routine screening and 17 -44% by symptoms) • A child suspected of having active TB may not yield any positive cultures/smears • Need the adult contact’s culture results for drug sensitivities and to determine treatment regimen for the child • A thorough contact investigation is critical in the evaluation, management, and prevention of TB infection in the child.

Thank you for your patience
- Slides: 92